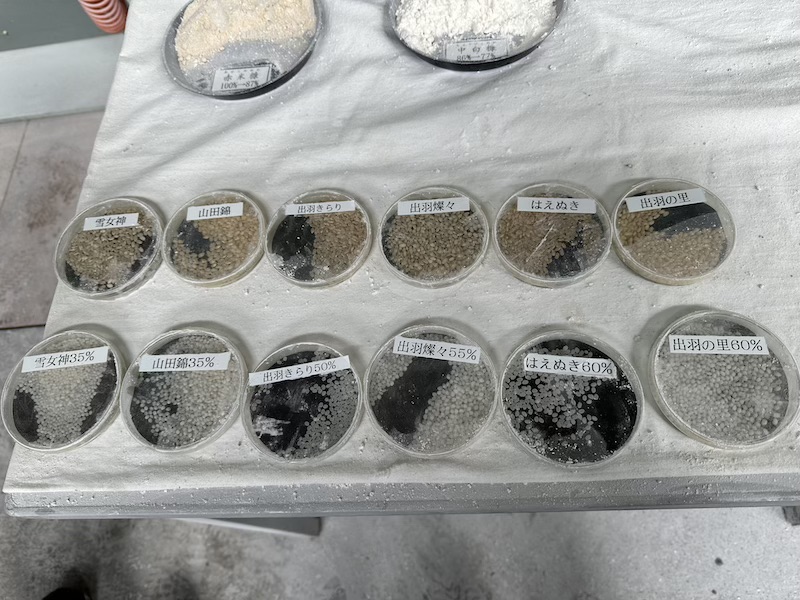

洌を醸す小嶋総本店さまにて
【小嶋総本店/山形県】
創業安土桃山(1597年)。米沢市にはかつて上杉家の居城 米沢城がありましたが、上杉家御用達の酒屋であったのが小嶋総本店です。山形県内でも特に豪雪地帯として知られる米沢市にあり、日本百名山 吾妻山からの雪解け水が織りなす最上川の源流に最も近い酒蔵とされています。蔵にある井戸からは米沢の年間平均気温と同じ11度の地下水が一年中湧き出ています。 代表銘柄の「東光 (とうこう)」は「米沢城の東側、朝日が昇る方角の酒」が由来です。県外でのみ展開される限定ブランド「洌 (れつ) 」は、繊細ながらハリのある旨味とキレが素晴らしく、その味わいは真冬の清流を思わせます。流行りに流されない王道のおいしさをお楽しみください。
山形空港到着です。


県内でも一番寒いと言われる米沢に蔵はあります。氷柱がなんとも言えない風情を感じました。朝の9時です。
極寒の中での仕込み。蔵内はとても清潔でした。
木桶も現役です。
小嶋総本店、安土桃山時代 創業当時の日本酒を再現した「甕仕込み」。醸造に耐えられる甕を造ることができる作家さんも今ではほとんどいないそうです。こちらの甕は、岡山・備前焼作家 松井氏の作品です。仕上がった酒はどこか陶器のミネラル分を感じました。
精米見本。
続いて資料館に。大変立派なお雛様に圧倒されました。
江戸時代に木桶が登場する前に使われていた安土桃山時代の甕。大変貴重な当時物です。
迫力のある木桶がズラーっと。
続いてテイスティングの時間です。
平成15年には現天皇、皇后両陛下が行啓されました。
蔵人さんのお誘いで昼食に。地元 米沢で大変人気のレストラン ミートピアさん。
米沢牛のすき焼き。
米沢の縁起物「おたかぽっぽ」。
帰りは雪景色の中、新幹線で帰阪しました。
小嶋総本店の皆さま、ありがとうございました。